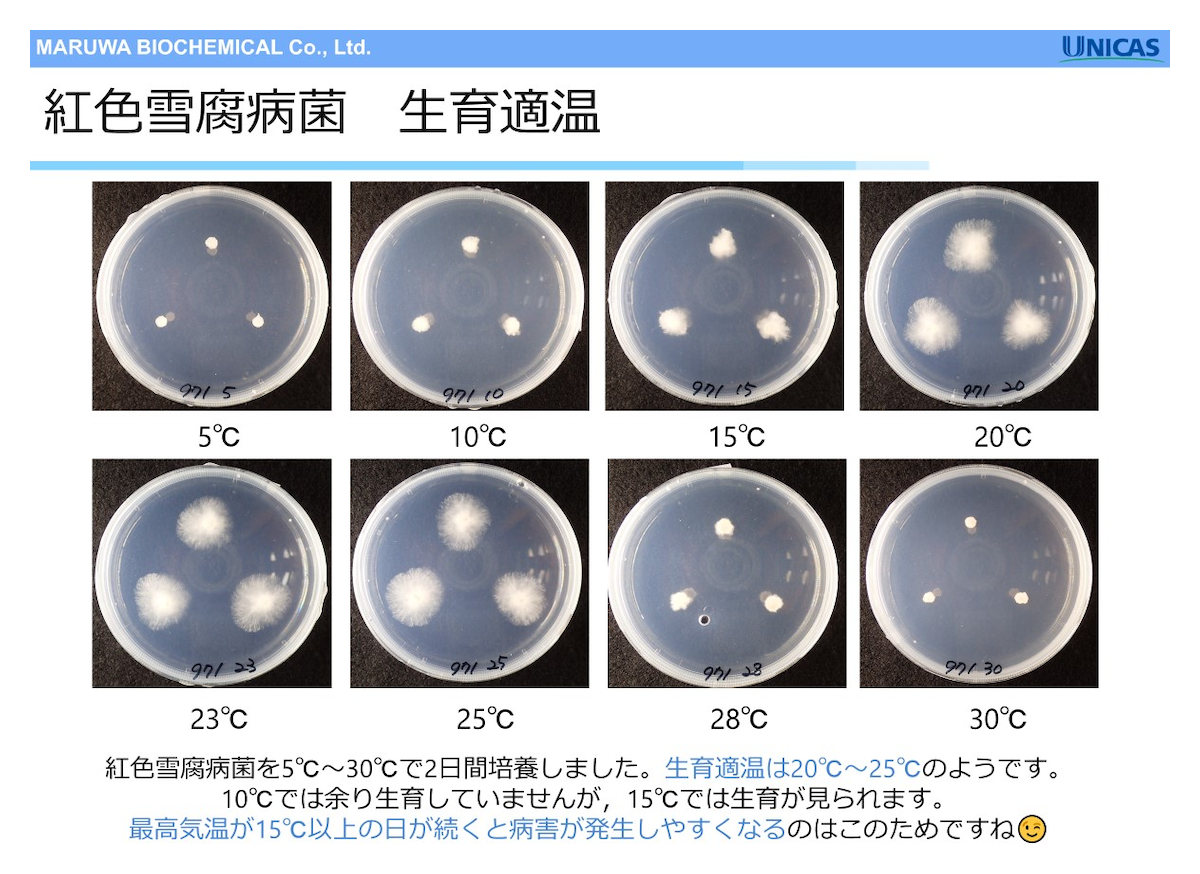
紅色雪腐病菌 生育適温

ユニカス事業部では2021年2月よりLINEを活用し、芝生に関する様々な情報配信を行っています。月ごとの病害予報や季節ごとの雑草に関する情報、営業担当者からの現地レポートなど、お役立ち情報を皆様に提供しております。
紅色雪腐病は雪が降らない地域でも冬から春に発生することがあります。2023年12月~2024年3月の紅色雪腐病に関する配信をまとめてご紹介します。
【LINEアーカイブ】紅色雪腐病(2023年12月20日配信)
先日(11/29)、近隣ゴルフ場のキーパーから秋に播種したベントグラスナセリに紅色雪腐病が出ているよ!と連絡を頂きました。
お手本のようなパッチが1つ出ていましたので、ソッドを切り取ってもらってきました。
ソッドを丸1日車の中に置きっぱなしにしていましたら菌糸が形成されました。
パッチ中心部には菌糸はなく、外周部に菌糸がビッシリ。パッチが外側にどんどん大きくなっていくのがよくわかりますね。

折角なので、パッチを直径3cmほどにくり抜いて、パイプハウス内のベントグラスに移植してみました。パイプハウス内では↓のような幅30cm、長さ2mのU字溝を並べてベントグラスを栽培しています。ハウス内の温度は13~25℃で管理しています。

11月29日にもらってきた紅色雪腐病のパッチを埋め込みました(○印部分)。
10日ほどで直径約3倍、20日ほどで約6倍に大きくなりました!
紅色雪腐病って言いますが、雪の積もらない地域では少し暖かい方が病気が進みやすいんですね。

【LINEアーカイブ】病害注意報(紅色雪腐病)(2024年2月9日配信)
今週の初め、関東地方では雪となりました。
立春を過ぎたとはいえ、まだまだ寒さが続くかと思っていましたら、来週は一気に季節が進んで4月並みの高温予報がでています。
最高気温が20℃近くになるところもあるようです。
陽気に誘われて、ベントグリーンに病害発生する可能性があります。ご注意ください。

【LINEアーカイブ】紅色雪腐病(2024年3月12日配信)
関東地方では先週雪が降りましたが、今週後半は暖かくなるようです。
来週には桜の便りも届きそうですね。
さて、2月9日に「病害注意報」で、少し暖かくなると”雪の積もらない地域の紅色雪腐病“が動きますよ・・・というお知らせをしました。2月には紅色雪腐病と診断したサンプルがたくさん届きました。
これから暖かくなるにつれて、もう一度紅色雪腐病が動く可能性があります。今回はその理由をご説明します。
この冬に紅色雪腐病が出たゴルフ場の皆さん! 要注意ですよ。

【LINEアーカイブ】紅色雪腐病(2024年3月18日配信)
先週末は暖かくなりましたが、春分の日は雪の予報が出ている地域もあります。春の陽気と寒の戻りを繰り返しながら、季節は進むようです。
さて、前回『紅色雪腐病菌の生育適温は20~25℃付近』だというお話しをしました。
この時に培養した菌を、余っていたベントグラスに接種してみました。
接種したベントグラスポットをポリ袋に入れて、10℃~25℃におきました。10日後にベントグラスの状態を確認しましたところ、15℃と20℃でしっかり発病していました。
『最高気温が15℃を超えると紅色雪腐病が動き出しますよ!』と何度かお話ししましたが、ポット試験の結果はその通り。本格的な春に向けて、もう一度紅色雪腐病が動く可能性があります。皆さん、ご注意くださいね!

芝生の病害図鑑
